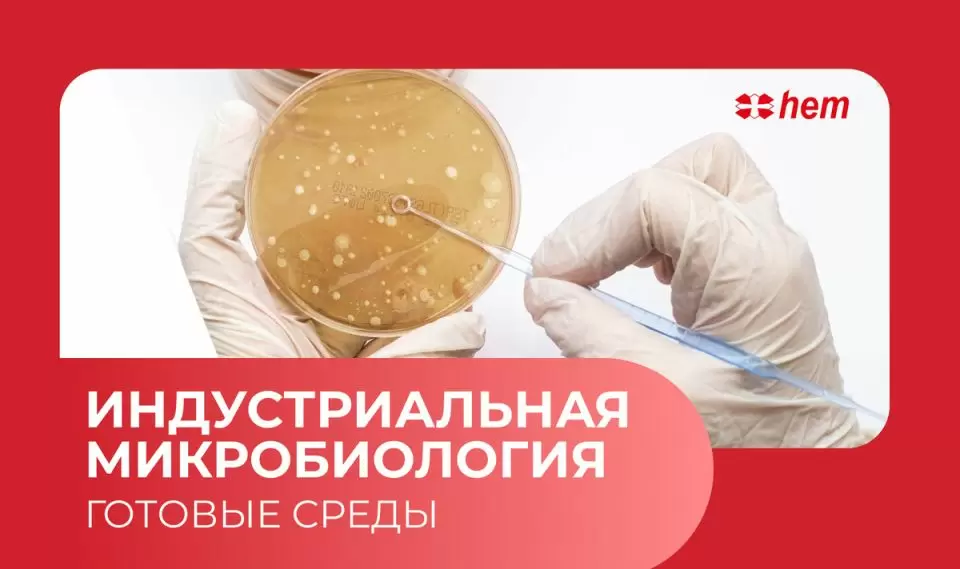

После пикировки начинается ключевой этап роста рассады томатов, перчиков и баклажанов. Учитывая важность этого времени, необходима тщательная забота об этих растениях, чтобы они развились сильными и здоровыми.
Правильный полив и уход
Первое, на что стоит обратить внимание, — это уровень влажности почвы. При пикировке земляная смесь должна быть умеренно влажной. Если по случайности произошло избыточное увлажнение, рекомендуется аккуратно раскидать землю сверху, используя тонкий предмет, например, зубочистку. Это поможет разбить корку и улучшить доступ воздуха к корням.
От слишком большого количества влаги образуется плотная корка, что мешает нормальному развитию растений. Чтобы ускорить просыхание кома, полезно добавить немного вермикулита на поверхность почвы. Этот материал отлично впитывает лишнюю влагу и помогает сохранить оптимальный уровень увлажненности.
Освещение и температурные условия
Нельзя забывать и о свете. Рассада должна находиться в условиях достаточного освещения, поэтому стоит периодически менять место ее размещения, например, чередуя южные и северные подоконники. Это позволяет растениям не только получать достаточно света, но и развиваться более гармонично, а также избежать излишнего вытягивания.
Температура и влажность в помещении оказывают большое влияние на частоту поливов. В среднем, рекомендуется поливать расаду 2-3 раза в неделю, увеличивая частоту полива в более теплые и солнечные дни. По мере роста рассады и с активным усилением солнечного света, стоит уделять особое внимание этому аспекту.
Подкормки и методы замедления роста
Подкормки играют важную роль в подготовке растений к пересадке. Рекомендуется провести две подкормки: одну через неделю-две после пикировки с использованием кальциевой селитры, а вторую за пару недель до высадки в грунт с использованием удобрения Фертикой Люкс. Альтернативно, можно воспользоваться настоем луковой шелухи или раствором древесной золы.
Чтобы замедлить рост рассады и способствовать развитию корневой системы, после пикировки не стоит заполнять стаканчики до краев. Это позволит растению перенаправить свои ресурсы на наращивание корней в засыпанной части ствола. Повторная пикировка, при которой рассада пересаживается в более просторные ёмкости, также может помочь в этом — корни будут активно осваивать новое пространство, что в конечном итоге поможет создать более крепкую и здоровую рассаду.